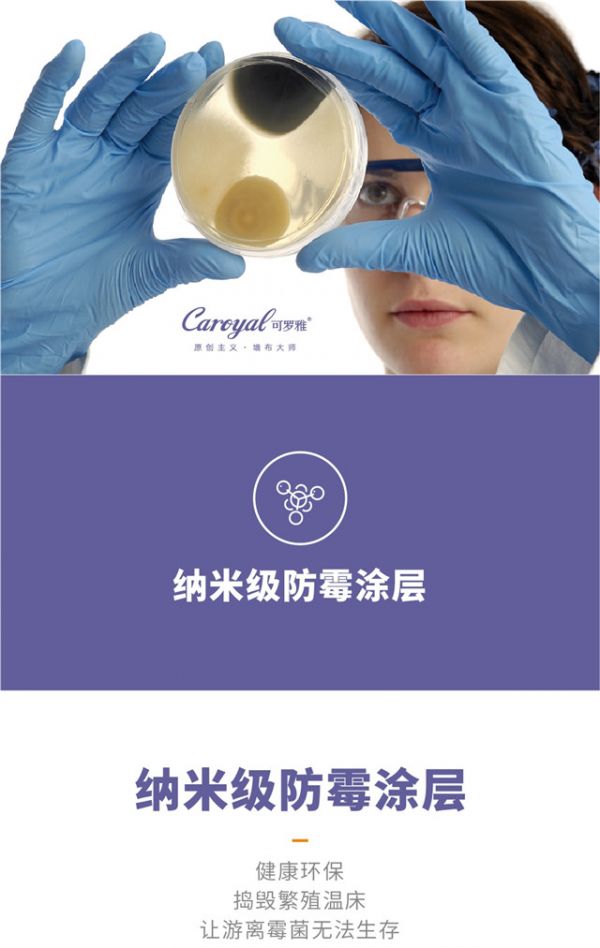

墙布的铺贴施工你真的会了吗?这些注意事项防踩雷!
都说“良好的开端,是成功的一半”,这句同样适用于墙布的铺贴施工,对于整个使用过程的重要作用!在此基础上,后期对墙布的保养,就能收到事半功倍的效果了。

CA128Z-30B / 《清晚云》
施工时的注意事项
○ 在墙布施工时,白天应打开门窗,保持通风;晚上要关闭门窗,防止潮气进入。刚贴上的墙布,如果遇到挟带大量湿汽的大风猛吹,会影响其粘接牢度。可罗雅墙布采用24H防水喷涂工艺,正面三防,水进不去,反面透气,水出得来!
可罗雅防水实验

独幅 /《眷恋》
○ 墙布,尤其是热胶墙布,在铺贴施工中,如果仅凭墙布自然的垂性直接烫平的话,就会出现俗称的“白条”或“黑印”,甚至是凹凸不平的“鼓包”。这时就需要用另一只手,顺着墙布的纹理,以自然的力道轻轻抻平,再施以熨烫铺贴就可以了。

CA130S-24B / 《颂歌》
○ 粘贴墙布时溢流出的胶水等,应随时用干净的毛巾擦去,尤其是接缝处的胶痕,要处理干净。这时一定要认真仔细地检查墙布胶有否溢出,如沾有污迹,应及时用清洁剂清洗干净。
使用中需要注意的地方

○ 如果家中有使用墙布做墙饰材料的,建议经常开窗户,保证通风循环,如果长期不对流,那么屋里潮湿就会导致霉菌在墙布上沉积、滋生,不仅影响到墙布的使用,对家人的身体健康也会带来很大的威胁。
可罗雅墙布采用纳米级防霉涂层,健康环保,捣毁繁殖温床,让游离霉菌无法生存!
○ 保养墙布需要长期坚持,不能长久地不打理,放任它的折旧。用户每天都用毛掸在墙布上扫一下,经常打理,避免墙布上面积累灰尘,每天都给家人带来洁净舒适的一天,何乐而不为呢?

○ 要想墙布在后续使用过程中状态更好,只要注意墙布的保养与清洁就可以了!对墙布沾染上的干性灰土污渍,只需用半湿的干净抹布擦拭即可,对于油性、酱油等较难清理的污渍,可用普通家用的洗涤剂,适当清洗就能达到很好的效果了。但要注意要及时处理,不要等到沾染牢靠了,再想清理就困难了。并且注意在用清水等液体清洁过程中,不要碰到墙布的粘接处,但是可罗雅墙布不仅防水,还有强大的防污效果!
可罗雅防污实验
合理地施工、保养墙布,定能给你一下洁净、靓丽的家居环境!
| 福利时刻 |
—接下来就是发红包的时间了....

一年一度的中秋佳节即将来临,为感谢一直关爱可罗雅墙布成长的每一位家人、朋友,我们特别准备了月饼喜好问卷,愿月饼的一抹香甜,与可罗雅墙布的一席温情,陪伴您与家人共同度过这个团圆佳节。请大家快快来留言告诉可罗雅:您最喜欢什么馅儿的月饼吧!

冰皮的、咸蛋黄的、水果馅的还是五仁的....等等多种口味,赶快留言吧!
对于评论区留言点赞最多的前三位朋友,我们将依次送出88元、68元、58元的现金红包,作为“月饼基金”。
还不止这样——我们还将在留言中,再随机选取数位幸运的朋友,送上8.8元的中秋现金红包,作为“香甜基金”。
愿这个中秋节,可罗雅有幸与您共度甜蜜团圆时刻!
网址:墙布的铺贴施工你真的会了吗?这些注意事项防踩雷! https://www.jiaju82.com/news-view-id-664321.html

